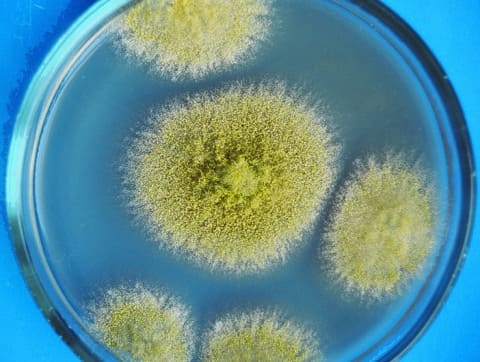
Аспергиллез

Аспергиллез – грибковое заболевание, вызываемое плесневыми грибами рода Aspergillus, поражающее человека и проявляющееся возникновением первичных очагов в легочной ткани, разнообразием клинических поражений, которые в случае выраженного иммунодефицита могут привести к летальному исходу.
Грибы рода Аспергилл широко распространены в природе и обнаруживаются в почве, в сене, зерне, в пыли различных помещений, особенно после обработки шкур и шерсти животных. Важным эпидемиологическим моментом является частое их высевание в пылевых частицах лечебно-профилактических учреждений, что определяет возможность возникновения внутрибольничных грибковых инфекций.

Аспергиллез
Причины возникновения аспергиллеза
Возбудитель – плесневые грибы рода Aspergillus, наиболее частым представителем которого является Aspergillus fumigatus (80% всех случаев аспергиллеза), реже Aspergillus vlavus, Aspergillus niger и другие. Грибы рода Aspergillus (или Aspergillus spp.) относятся к плесневым грибам, термоустойчивы, благоприятным условием для существования является повышенная влажность. Грибы рода Aspergillus часто представлены в жилых помещениях, нередко обнаруживаются на поверхности непригодных к употреблению продуктов питания. Патогенные свойства аспергилл определяются способностью выделять аллергены, что проявляется тяжелыми аллергическими реакциями, поражением легких, примером которых может быть бронхолегочной аспергиллез. Также некоторые из представителей грибов могут выделять эндотоксин, способный вызвать интоксикацию. Аспергиллы устойчивы к высыханию, длительно могут сохраняться в пылевых частицах. Губительно на грибы действуют растворы формалина и карболовой кислоты.
Механизм заражения – аэрогенный, а основной путь – воздушно-пылевой: с частицами пыли в дыхательные пути попадают грибы данного рода. Существуют профессиональные группы риска для заражения аспергиллезом: сельскохозяйственные работники; сотрудники ткацких фабрик и прядильных предприятий, а также иммунодефицитные пациенты лечебных стационаров, которые подвержены внутрибольничному риску инфицирования.
Дополнительный механизм заражения – эндогенное инфицирование аспергиллами в случае, если грибы данного рода уже присутствуют на слизистых оболочках. Основной фактор, способствующий эндогенному распространению инфекции – иммунодефицит, при котором в 25% случаев развиваются микозы различной этиологии, но основную долю из которых (до 75%) составляет аспергиллез.
Человек, больной аспергиллезом, для окружающих не заразен, таких случаев не описано.
Восприимчивость населения всеобщая, однако заболевают лица с ослабленным иммунитетом в ходе хронических заболеваний, онкологических процессов, после пересадки органов и тканей, при ВИЧ-инфекции и других. Сезонности при аспергиллезе не отмечено.
Иммунитет после перенесенной инфекции нестойкий, случаются повторные заболевания в группе иммунодефицитных больных.
Патогенное действие Aspergillus spp. на человека
Входными воротами инфекции в подавляющем большинстве случаев является слизистая оболочка верхних дыхательных путей. Сначала аспергиллы располагаются поверхностно, затем углубляются, вызывая изъязвления слизистой оболочки.

Аспергиллез, место поражения
1) Даже у здорового человека при вдыхании большой концентрации спор аспергилл может развиться воспаление легких – интерстициальная пневмония. Отличительной особенностью интерстициальной пневмонии при аспергиллезе является образование специфических гранулем, состоящих из гигантских клеток эпителия (так называемые эпителиоидноклеточные гранулемы). Аспергиллезные гранулемы (аспергилломы) имеют шарообразную форму и представляют собой центрально расположенные очаги гнойного воспаления, в которых и находятся гифы грибов, а по периферии гигантские клетки. Места локализаций аспергиллом – это верхние отделы легких, что подтверждается на рентгенограмме. Грибы обнаруживаются в пораженной слизистой оболочке бронхов, в полостях легких, бронхоэктатических очагах и кистах, в ткань легких при данной форме грибы не проникают (неинвазивный аспергиллез).
2) Параллельно с поражением дыхательной системы при аспергиллезе имеет место снижение иммунологический реактивности организма (иммунодефицит). Описаны случаи осложнений сопутствующих болезней внутренних органов, слизистых оболочек и кожных покровов. Примером могут являться абсцессы легкого, хронический бронхит, бронхоэктатическая болезнь, рак легких, туберкулез, на фоне которых возникала легочная форма аспергиллеза, что, безусловно, вызывало осложнение основного процесса. Последние десятилетия показывают частоту возникновения аспергиллеза у иммунокомпроментированных лиц (ВИЧ-инфицированные, онкологические больные, получающие иммуносупрессивную терапию, реципиенты органов).
3) Одно из возможных поражений при аспергиллезе – поражение внутренних органов и систем (инвазивный аспергиллез), встречающийся в подавляющем большинстве случаев на фоне существенного снижения иммунитета. До 90% пациентов с данным поражением имеют две из возможных трех особенностей:
• число гранулоцитов в крови менее 500 клеток в 1 мкл.;
• терапия высокими дозами глюкокортикостероидов;
• терапия цитостатиками.
При инвазивном аспергиллезе аспергилломы могут образовываться во внутренних органах. Занос грибов происходит гематогенно ( с током крови). Сначала поражаются легкие, в последующем плевра, лимфатические узлы и другие внутренние органы. Особенность – возможность формирования абсцессов на месте гранулем в большинстве случаев. Характер процесса напоминает септический, при котором летальность достаточно высока (до 50%).
4) Аллергическая перестройка организма – антигены гриба являются мощными аллергенами, способными вызвать аллергические реакции с преимущественным поражением бронхолегочного дерева.
Симптомы аспергиллеза
Инкубационный период высчитать не представляется возможным – нет четкой связи момента инфицирования с появлением первых симптомов болезни.
Аспергиллез классифицируют как инвазивный (чаще поражаются места внедрения возбудителя – пазухи носа, кожа, нижние дыхательные пути), сапрофитичсекий (отомикоз, аспергиллема легких) и аллергический (бронхолегочной аллергический аспергиллез, аспергиллезный синусит).
Клинически выделяют следующие формы болезни:
1) бронхолегочная форма;
2) септическая форма;
3) глазная форма;
4) кожная форма;
5) поражение ЛОР-органов;
6) поражение костей;
7) прочие более редкие формы аспергилеза (поражение слизистых оболочек ротовой полости, половой системы и другие).
Бронхолегочная форма – самая частая форма аспергилеза, характеризуется симптомами трахеита, бронхита или трахеобронхита. Больные жалуются на слабость, появление кашля с мокротой серого цвета, возможно с прожилками крови, с небольшими комочками (скопления грибов). Течение болезни хроническое. Без специфического лечения заболевания начинает прогрессировать – поражаются легкие с возникновением пневмонии. Пневмония развивается либо остро, либо осложняет течение хронического процесса. При остром ее возникновении у пациента повышается температура до 38-39°С, лихорадка неправильного типа (максимум утром или в обед, а не в вечернее время, как обычно). Больного знобит, беспокоит выраженный кашель с вязкой мокротой слизисто-гнойного характера или с кровью, одышка, боли в груди при кашле и дыхании, снижение веса, отсутствие аппетита, нарастающая слабость, обильная потливость. При осмотре выслушиваются влажные мелкопузырчатые хрипы, шум трения плевры, укорочение перкуторного звука.

Аспергиллез, бронхолегочная форма
При микроскопии мокроты обнаруживаются зеленовато-сероватые комочки, содержащие скопления мицелия аспергилл. В периферической крови выраженный лейкоцитоз (до 20*109/л и выше), увеличение СОЭ, повышение эозинофилов. Рентгенологически – воспалительные инфильтраты округлых или овальных форм с инфильтративным валом по периферии, имеющие склонность к распаду.
При хроническом течении аспергиллеза бурных симптомов не возникает, грибковый процесс чаще наслаивается на уже имеющееся поражение (бронхоэктаз, абсцесс и другое). Больные часто жалуются на запах плесени изо рта, изменение характера мокроты с зеленоватыми комочками. Только рентгенологически отмечают возникновение в имеющихся полостях шарообразных затенений с наличием воздушной газовой прослойки со стенками полости – так называемая «серповидная ореола».

Аспергиллез легких, серповидная ореола
Прогноз выздоровления при бронхолегочной форме зависит от остроты течения процесса и состояния иммунитета и составляет от 25 до 40%.
Септическая форма аспергиллеза возникает при резком угнетении иммунитета (например, стадия СПИД при ВИЧ-инфекции). Процесс протекает по типу грибкового сепсиса. Наряду с первичным поражением легких прогрессирующе нарастает вовлечение в процесс внутренних органов и систем организма больного, распространение грибковой инфекции происходит гематогенно. По частоте поражения это пищеварительная система - гастриты, гастроэнтериты, энтероколиты, при которых пациенты предъявляют жалобы на неприятный запах плесени изо рта, тошнота, рвота, расстройства стула с выделением жидкого стула с пеной, содержащей мицелии гриба. Нередко встречаются поражения кожи, органов зрения (специфические увеиты), головного мозга (аспергилломы в головном мозге). Если аспергиллез развивается у ВИЧ-инфицированного, то болезни сопутствуют другие оппортунистические инфекции (кандидоз, криптоспоридиоз, пневмоцистная пневмония, саркома Капоши, герпетическая инфекция). Прогноз при заболевании чаще неблагоприятный.
Аспергиллез ЛОР органов протекает с развитием отитов наружных и средних, поражением придаточных пазух носа - синуситы, гортани. При поражении глаз формируются специфические увеиты, кератиты, реже эндофтальмиты. Прочие формы болезни встречаются крайне редко. Аспергиллез костной системы проявляется возникновением септических артритов, остеомиелитов.
Особенности течения аспергиллеза у ВИЧ-инфицированных больных.
Аспергиллез представляет собой наиболее частую форму грибковых поражений в данной группе больных. Все пациенты находятся в последней стадии ВИЧ-инфекции – стадии СПИДа. Быстро развивается аспергиллезный сепсис, имеющий тяжелое течение и прогноз. Количество CD4 обычно не превышает 50/мкл. Рентгенологически выявляют двусторонние очаговые затенения шаровидной формы. Наряду с легкими поражаются органы слуха (отомикоз), поражение зрения с развитием кератитов, увеитов, эндофтальмита, нередко может поражаться сердечно-сосудистая система (грибковое поражение клапанного аппарата сердца, эндокардит, миокардит).
Осложнения при аспергиллезе встречаются при отсутствии специфического лечения и на фоне иммунодефицита и представляют собой возникновение обширных абсцессов, хронической обструктивной болезни легких, фиброза легких, поражение внутренних органов.
Прогноз заболевания при иммунодефицитах неблагоприятный.
Диагностика аспергиллеза
Предварительный диагноз – клинико-эпидемиологический. Появление определенных симптомов болезни в комплексе с данными по наличию специфической профессии, наличию сопутствующего заболевания и иммуносупрессивной терапии, а также выраженного иммунодефицита склоняют доктора в пользу возможного аспергиллеза.
Окончательный диагноз требует лабораторного подтверждения болезни.
1) Микологическое исследование материала (мокроты, материала бронхов - смывы, биоптатов пораженных органов, соскобов слизистых оболочек, мазков-отпечатков). Из крови выделение грибов происходит редко, поэтому диагностическое исследование крови не представляет ценности.
2) Серологическое исследование крови с целью выявления антител к аспергиллам (ИФА, РСК), увеличение концентрации IgE.
3) Параклинические исследования: общий анализ крови: лейкоцитоз, эозинофилия, увеличение СОЭ.
4) Инструментальные исследования: рентгенологическое исследование, КТ легких (обнаружение шаровидных или овальной формы объемных инфильтратов односторонних или симметричных, выявление шаровидных инфильтратов в имеющихся ранее полостях с серповиным просветлением по периферии).
5) Специальные исследования: бронхоскопия, бронхиальные смывы, бронхоальвеолярный лаваж или трансторакальная аспирационная биопсия с последующим изучением образцов с целью выявления патоморфологических изменений: гистологически выявляются очаги некрозов, гемморогические инфаркты, поражение сосудистого звена инвазивного характера, обнаружение гифов аспергилл.
Аспергиллез, рост гриба в материале
Дифференциальный диагноз проводится с поражениями легких другой грибковой этиологии (кандидоз, гистопалзмоз), туберкулезом легких, раком легких, абсцессом легких и другими.
Лечение аспергиллеза
Организационно-режимные мероприятия включают в себя госпитализацию по показаниям (тяжелые формы болезни, инвазивный аспергиллез), постельный режи весь лихорадочный период, полноценная диета.
Лечебные мероприятия включают в себя хирургические методы и консервативную терапию.
1) Консервативная медикаментозная терапия представляет сложную задачу и представлена назначением противомикотических препаратов: итраконазол 400 мг/сутки внтутрь длительными курсами, амфотерицин В 1-1,5 гр/кг/сут внутривенно при выраженных иммунодефицитах, вориконазол 4-6 мг/кг 2 р/сут внутривенно, поспаконазол 200 мг 3 р/сут внутрь, каспофунгин 70мг-50 мг внутривенно. На фоне лечения титры антител к аспергиллам имеют тенденцию к повышению с последующим постепенным снижением. Терапия дополняется общеукрепляющими препаратами, витаминотерапией. Все препараты имеют противопоказания и назначаются исключительно врачом и под его контролем.
2) Хирургические методы: проведение лобэктомии с удалением пораженных участков легкого.
Нередко такие методы оказываются эффективными и подтверждаются отсутствием рецидивов болезни. При распространении процесса подключают консервативную терапию.
Эффективность лечения выше при использовании возможности снижения дозировок сопутствующей глюкокортикостероидной и иммуносупрессивной терапии.
Профилактика аспергиллеза
1) Своевременная и ранняя диагностика заболевания, своевременное начало специфического лечения.
2) Проведение медицинских осмотров в группах профессионального риска (сельхозработники, сотрудники ткацких фабрик и прядильных предприятий).
3) Настороженность в плане возможного аспергиллеза в группе лиц, страдающих иммунодефицитами на фоне приема иммуносупрессивной терапии, тяжелых инфекций (ВИЧ и другие). Положительные серологические реакции на антитела к аспергиллам требуют тщательного обследования пациента на предмет заболевания.
Врач инфекционист Быкова Н.И.




Комментарии
правильный и быстрый диагноз - это правильное лечение.
для постановки диагноза:
не бойтесь советоваться.
1. сначала поговорите с поговорите с практикующим ЛОР врачом.
2. поговорите с практикующим врачом - инфекционистом.
3. вас скорее всего направят на клинический и биохимический анализ крови. - эти анализы покажут состояние внутренних органов, крови иммунитета и определят, что делать дальше.
если есть подозрения на грибковые причины болезни - вам нужно сдать анализ на "смесь аллергенов плесени" IgE IgG.
4. сдайте мазок из горла "на посев" в любой медицинской лаборатории (на предмет определения всех микроорганизмов которые они могут определить). и такой же мазок на пцр.
5. самое -главное - посоветуйтесь с практикующим хирургом (лор) по поводу шишки под языком.
6. после чего ситихает, а после чего провоцируется, какие вы лекарства принимаете (прописанные и непрописанные) - это тоже изложите врачам.
7. зайдите на прием к аллергологу.
самолечение без диагностики - это тыкать пальцем в небо и терять время.